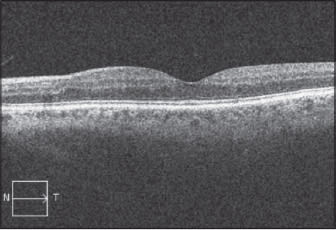

Early Vitrectomy for DME: Does It Have a Role?
Sometimes vitrectomy can be first-line treatment. Part 1 of 2.
MAURICE B. LANDERS, III, MD • VERONICA A. KON GRAVERSEN, MD • MICHAEL W. STEWART, MD
The microvascular changes that result from diabetes mellitus (retinopathy, nephropathy and neuropathy) result in significant morbidity and high rates of disability. Of these, diabetic retinopathy affects the largest number of individuals (5.3 million in the United States alone) and with sufficient disease duration, will plague nearly all diabetics.
Diabetic macular edema is the major reason for vision loss among diabetics and is the leading cause of vision loss in the working-age population of the industrialized world. Because health-care costs for patients with diabetic retinopathy are 30% higher than those without retinopathy, DME is understandably considered a major public health concern.
The World Health Organization estimated that the number of diabetics will increase from 171 million in 2000 to 366 million by 2030, thus affecting 4.4% of the world’s population.1 Although developing countries currently report lower rates of DR, as their populations age, become more obese, and gain improved access to medical care, these rates are likely to increase.
For the past 30 years, macular laser photocoagulation has been considered the “gold standard” for the treatment of DME. However, because patients with diffuse DME rarely achieve significant improvements in visual acuity, physicians have attempted to improve the results of treatment by first injecting corticosteroids and, more recently, drugs that inhibit the actions of vascular endothelial growth factor into the vitreous cavity.
Unfortunately, these treatments are expensive and require frequent examinations and injections that can go on for years, possibly even indefinitely. This need for long-term treatment increases the chance of an adverse event so that after 20 to 40 injections, the cumulative risk of endophthalmitis approaches or exceeds 1%.2
| Maurice B. Landers, III, MD, is on the faculty and Veronica A. Kon Graversen, MD, is a resident in the Department of Ophthalmology at the University of North Carolina School of Medicine in Chapel Hill. Michael W. Stewart, MD, is chair of the Department of Ophthalmology at the Mayo Clinic in Jacksonville, FL. None of the authors reports any financial interests in any products mentioned in this article. Dr. Landers can be reached via e-mail at reecelanders@gmail.com. |
Manpower projections, moreover, suggest that the number of trained ophthalmologists may be insufficient to care for the increasing number of diabetic patients. Spiraling health-care costs will call into question society’s ability to provide increasingly expensive care.
What physicians and patients both need is a treatment for DME with the following qualities: efficacy, safety, durability, low cost, the need for infrequent examinations, and availability. In response to these needs, this article proposes that pars plana vitrectomy, done early in the course of a case of nonproliferative diabetic retinopathy with vision-compromising DME, may well meet these criteria.
VITRECTOMY ELIMINATES MACULAR EDEMA
The hallmark of any effective treatment for DME is the ability to promote drying of the retina. This requires the establishment of a favorable physiologic balance by minimizing fluid leakage into the retina (through the retinal vasculature walls and retinal pigment epithelium) without compromising resorption of excess fluid.
Nearly two decades of clinical experience has demonstrated that vitrectomy effectively restores the blood-retinal barrier and significantly thins the macula.
Vitrectomy for DME was first described in a group of 10 patients with taut posterior hyaloids, nine of whom achieved improved vision.3 Not until nine years later was the presence of retinal thickening in eyes with taut posterior hyaloids confirmed with OCT.
Subsequent surgical series resulted in improved vision in these eyes, leading most surgeons to agree that vitrectomy benefits these patients. However, what should be done for the much larger group of DME patients who do not have taut hyaloids? These are the challenging patients at whom the balance of this article is aimed.
Encouraged by improvement in eyes with taut hyaloids, surgeons began operating on eyes without vitreomacular traction. These were uncontrolled, retrospective series with improvement measured by changes in VA and the clinical appearance of the macula.
| Table. Important characteristics of anti-VEGF therapy contrasted with those of vitrectomy | ||
|---|---|---|
| CHARACTERISTIC | ANTI-VEGF THERAPY | VITRECTOMY |
| EFFICACY | Excellent drying of macula; vision improvement of seven to 10 letters. | Excellent drying of macula; vision improvement not yet well defined. |
| SAFETY | Endophthalmitis rate: 0.5% to 1.4%. | Retinal Detachment rate: 1.5%. |
| DURABILITY | Decreased frequency of treatments after one year (two to five per year). | Long-lasting effect (years) after single surgery. |
| COST | First year: $17,764. | First year: $5,402. |
| NEED FOR INFREQUENT EXAMS | Frequent exams (monthly) to rule out recurrent edema. | Every six to 12 months after initial postoperative period. |
| AVAILABILITY | Ranibizumab not covered by all insurance carriers. | Vitrectomy covered by insurers. |
Although these reports were encouraging, their primitive study designs and nonquantitative descriptions of macular changes (no OCT measurements), before and after vitrectomy, meant that they simply fulfilled the role of early pilot studies.
Subsequent studies included prospective enrollment, time-domain OCT measurements of the macula, which did not allow for detailed analysis of external limiting membrane and inner segment/outer segment junction, and, finally, the inclusion of control arms. Dozens of reports on the effect of vitrectomy on DME have been published since 2000, and most of them have included OCT data, but only with TD-OCT results.
The results of these studies have varied considerably, and unfortunately, none has provided level 1 evidence for the effectiveness of vitrectomy as the primary treatment fr DME. However, when analyzed collectively, these studies give us insight into the strengths and weaknesses of vitrectomy as a potential treatment for DME.
We performed a Medline search for English-language manuscripts reporting vitrectomy for DME published since 2002. We identified 37 studies (1,881 patients), which we pooled according to study design, length of follow-up, and the performance of previous macular laser photocoagulation (Table).4-40
In aggregate, these studies report excellent thinning of the macula (weighted average change of −187 μm), which compares favorably with that achieved by intravitreal injections of anti-VEGF drugs with or without laser photocoagulation (range: -80 μm to −194 μm).41-44
The rapidity with which vitrectomy resolves DME and the durability of this effect were also very impressive (Figures 1 and 2, page 50). In the several different reports that have been published, macular thinning of −120 μm, or more than half of excessive thickness, has been observed at one week and more than 80% of the excess edema resolves by four weeks.20
Furthermore, studies with follow-ups of at least 12 months reported greater thinning than those with shorter follow-ups. The study with the longest follow-up — up to 170 months (mean of 74 months) — reported no regression after the first year.30 These studies demonstrate that macular edema resolves quickly after vitrectomy and that the effect is long lasting (Figure 3, page 52).
Studies of eyes that had previously received macular laser also demonstrated impressive macular thinning after vitrectomy. This was true for both retrospective (−242 μm) and prospective (−198 μm) studies. In a single-center, comparative, retrospective study, eyes that underwent vitrectomy achieved greater thinning at six months compared to those treated with laser or triamcinolone alone (−92 μm vs −28 μm vs −83 μm).45
VITRECTOMY IS SAFE
Fortunately, modern pars plana vitrectomy for macular conditions provides excellent anatomic and visual results with acceptable safety profiles; even 20-gauge vitrectomy has been reported to result in a 99% success rate for retinal detachments.46
Recently presented vitrectomy studies, with more than 100 cases in each, have reported 100% success rates for 118 cases for macular holes,62 398 cases for visually significant floaters,63 and no cases of retinal detachment in 403 cases undergoing vitrectomy for macular pathology.47 None of these surgeons reported any cases of significant, vitrectomy-induced vision loss.


Figure 1. A preoperative photograph (left) shows nonproliferative DR with a large area of thickening in the superior macula. Six months after vitrectomy with ILM removal (right), the image shows resolution of the macular edema and significant regression of the DR.

Figure 2. Preoperative SD-OCT (left ) shows significant macular edema with cystoid fluid accumulation in a patient with background DR. A one-month posoperative SD-OCT image (right) shows significant improvement in macular thickness and resolution of the cystoid spaces.
Most vitrectomy for DME studies used 20-g instruments, but more recent series have used 23-and 25-gauge instruments. Smaller-gauge surgeries generally require shorter operating times, produce less postoperative discomfort, and may result in fewer iatrogenic tears and retinal detachments. Lower incidence of retinal detachment has been described following 25-g vitrectomy compared with 20-g.48
Because vitrectomy removes the scafold (cortical vitreous and ILM) onto which neovascularization grows, it may mask progressive ischemia and divert neovascularization to the vitreous base and anterior segment.49 In the 37 studies of vitrectomy for DME that we reviewed, however, there was little mention of rubeosis irides as a complicating factor.
This excellent safety profile appears to extend to vitrectomy for DME, although sight-threatening complications have been reported. The incidence of retinal tears during vitrectomy for DME ranges from 9% to 36%, but these cases did not affect final VA. Postoperative retinal detachments were reported in 13 of 1,881 eyes (0.7%), and most were repaired without adverse sequellae.
Postoperative growth of epimacular membranes has been seen in up to 36% of eyes that did not undergo ILM removal, and a few cases of vitreous hemorrhages have been described after ILM peeling.50 These complications are manageable, and the incidence of surgically induced vision loss was miniscule.
VITRECTOMY IS COST-EFFECTIVE
The treatment of patients with DME currently lasts for years and incurs high costs, particularly during the first few years. Although the average number of ranibizumab injections in long-term trials appears to decrease during years 2 (3 to 3.7) and 3 (2 to 2.7),51,52 patients still must have regular exams and imaging.
Published cost analyses have examined the one-year costs but have not yet evaluated the longer-term costs. Comparing the costs of different treatment strategies is complex, particularly if one attempts to correlate these costs with the amount of vision gained.
Using Medicare-allowable charges, however, the authors calculated the costs of one year of initial therapy. Monthly ranibizumab therapy was most expensive ($17,764), whereas monthly bevacizumab ($4,325) and vitrectomy ($5,402) were considerably less expensive (Table, page 47).
This discussion addresses only the direct costs of DME care, but the frequent clinic visits required by an anti-VEGF treatment regimen carry additional, significant indirect costs. Travel costs to and from the doctor’s oice have not been calculated, and productivity loss accrues due to time away from work for both the patient and those individuals accompanying him or her.
LIMITATIONS OF VITRECTOMY
Although vitrectomy consistently decreases macular edema in DME cases, significant visual improvement has, thus far, been much less common. This may well be the result of the vitrectomies in essentially all of these studies only having been done as a “last-ditch” procedure, after all other forms of treatment had failed. Very possibly, significant, permanent damage had already been done to the retina.
Without the availability of preoperative predictors of potential visual acuity in these eyes, such as SD-OCT measurements of the IS/OS or ELM lines,26 the postvitrectomy measurements of visual acuity in these older studies are meaningless.
Some authors believe that the timing of vitrectomy may be an important determinant of final VA and that early vitrectomy, relative to the duration of DME, yields better visual results.20 Delaying the institution of therapy for other exudative maculopathies (branch RVO, exudative AMD) by 21 to 24 weeks results in poorer long-term VA.53,54
Following vitrectomy, macular thinning occurs quickly (with many studies demonstrating more than 100 μm by the one-month postoperative exam), although the rapidity of VA improvement is not well documented in the literature. Some studies have shown that VA improvement does not correlate well with thinning of the macula because many eyes experience thinning without visual improvement.55

Figure 3. Data from several reported series showed improvement in central macular thickness following vitrectomy.
Unfortunately, these and most other studies have lacked good morphological predictors of visual improvement. Thus, it appears that macular thinning is necessary for, but not always sufficient to cause, improvement in VA. Other as yet poorly understood factors may limit visual recovery after vitrectomy. These may include photoreceptor damage, disruption at the IS/OS junction, and bipolar cell dysfunction.
Studies have suggested that disruption of the ELM and/or IS/OS junction, possibly combined with preoperative macular thickness, is the strongest predictor of postoperative VA.16,26,34
A retrospective study showed that the best predictors of postvitrectomy improvement in VA were preoperative integrity of the ELM (P = .0277) and IS/OS (p=0.03) lines,26 and a prospective study showed that IS/OS integrity, combined with central retinal thickness, best predicted postoperative visual improvement.64
RATIONALE FOR VITRECTOMY
The idea that vitrectomy thins the retina in eyes with DME is based on work from Duke in the early 1980s.56-58 Animal studies have shown that removing the vitreous and replacing it with saline improved the difusion of molecules, including oxygen, throughout the vitreous cavity by several fold.59
Reports of DME in 50% of eyes without posterior vitreous detachments but in only 20% of eyes with PVDs further supported this rationale.60 Additionally, resolution of DME was observed in 55% of eyes experiencing spontaneous PVDs but in only 25% of eyes that did not develop PVDs.55
Although the exact mechanism responsible for these differences is not known, the presence of highly oxygenated preretinal aqueous, as discovered in these early vitrectomy experiments, is a plausible explanation.
Neither these early studies nor the subsequent series describing vitrectomy for DME, however, described the amount of vitreous removal necessary to increase the circulation of oxygen-enriched aqueous to the preretinal space. None of these studies answered the question, “Does a spontaneous vitreous detachment improve the oxygen tension within an ischemic retina?”
We lack sufficient data to answer this question for two reasons. We do not have information regarding changes in intraretinal oxygen concentrations following vitreous detachments. Furthermore, histopathologic studies have shown that spontaneous vitreous detachments are often confused with the development of vitreous schisis cavities in diabetic eyes because some cortical vitreous usually remains adherent to the ILM.
Residual vitreous also remains after the induction of a vitreous detachment during vitrectomy. In many cases, premacular vitreous remnants may limit the diffusion of oxygen into the retina and interfere with VEGF removal from the retina.61 In contrast, thorough removal of the precortical vitreous and careful peeling of the ILM appear to decrease the incidence of postoperative ERM growth.
Taken together, these data suggest that residual vitreous may interfere with the resorption of DME, so consideration should be given to ILM removal during vitrectomy for DME. RP
REFERENCES
1. Wild S, Roglic G, Green A, et al. Global Prevalence of Diabetes. Estimates for the year 2000 and projections for 2030. Diabetes Care. 2004;27:1047-1053.
2. McCannel CA. Meta-analysis of endophthalmitis after intravitreal injection of anti-vascular endothelial growth factor agents: causative organisms and possible prevention strategies. Retina. 2011;31:654-661.
3. Lewis H, Abrams GW, Blumenkranz MS, Campo RV. Vitrectomy for diabetic macular traction and edema associated with posterior hyaloidal traction. Ophthalmology. 1992;99:753-759.
4. Doi N, Sakamoto T, Sonoda Y, et al. Comparative study of vitrectomy versus intravitreous triamcinolone for diabetic macular edema on randomized paired-eyes. Graefes Arch Clin Exp Ophthalmol. 2012;250:71-78.
5. Hoerauf H, Bruggemann A, Muecke M, et al. Pars plana vitrectomy for diabetic macular edema. Internal limiting membrane delamination vs. posterior hyaloid removal. A prospective randomized trial. Graefes Arch Clin Exp Ophthalmol. 2011;249:997-1008.
6. Diabetic Retinopathy Clinical Research Network Writing Committee; Haller JA, Qin H, Apte RS, et al. Vitrectomy outcomes in eyes with diabetic macular edema and vitreomacular traction. Ophthalmology. 2010;117:1087-1093.
7. Flaxel CJ, Edward AR, Aiello LP, et al. Factors associated with visual acuity outcomes after vitrectomy for diabetic macular edema: diabetic retinopathy clinical research network. Retina. 2010;30:1488-1495.
8. Navarro A, Pournaras JAC, Hoffart L, et al. Vitrectomy may prevent the occurrence of diabetic macular edema. Acta Ophthalmologica. 2010;88:483-485.
9. Shiba T, Kamura Y, Yagi F, Sato Y. Comparison of surgical procedures for vitreous surgery in diabetic macular edema. Jpn J Ophthalmol. 2009;53:120-124.
10. Park JH, Woo SJ, Ha YJ, Yu HG. Effect of vitrectomy on macular microcirculation in patients with diffuse diabetic macular edema. Graefes Arch Clin Ophthalmol. 2009;247:1009-1017.
11. Kang SW, Park SC, Cho HY, Kang JH. Triple therapy of vitrectomy, intravitreal triamcinolone, and macular laser photocoagulation for intractable diabetic macular edema. Am J Ophthalmol. 2007;144:878-885.
12. Hernandez-DaMota SE, Chacon-Lara A, Hernandez-Vazquez E. Use of triamcinolone and bevacizumab in 25 ga phaco-vitrectomy surgery for the treatment of cataract and diabetic macular edema. Arch Soc Esp Oftalmol. 2008;83:293-300.
13. Figueroa MS, Contreras I, Noval S. Surgical and anatomical outcomes of pars plana vitrectomy for diffuse nontractional diabetic macular edema. Retina. 2008;28:420-426.
14. Patel JI, Hykin PG, Schadt M, et al. Pars plana vitrectomy with and without peeling of the inner limiting membrane for diabetic macular edema. Retina. 2006;26:5-13.
15. Recchia FM, Ruby AJ, Carvalho Rechia CA. Pars plana vitrectomy with removal of the internal limiting membrane in the treatment of persistent diabetic macular edema. Am J Ophthalmol. 2005;139:447-454.
16. Yanyali A, Nohutcu AF, Horozoglu F, Celik E. Modified grid laser photocoagulation versus pars plana vitrectomy with internal limiting membrane removal in diabetic macular edema. Am J Ophthalmol. 2005;139:795-801.
17. Kumar A, Sinha S, Azad R, et al. Comparative evaluation of vitrectomy and dye-enhanced ILM peel with grid laser in diffuse diabetic macular edema. Graefes Arch Clin Exp Ophthalmol. 2007;245:360-368.
18. Bahadir M, Ertan A, Mertoglu O. Visual acuity comparison of vitrectomy with and without internal limiting membrane removal in the treatment of diabetic macular edema. Int Ophthalmol. 2005;26:3-8.
19. Lovestam-Adrian M, Larsson J. Vitrectomy seems to be beneficial for advance diffuse diabetic macular oedema not responding to laser treatment. Int Ophthalmol. 2005;26:21-26.
20. Kimura T, Kiryu J, Nishiwaki H, et al. Efficacy of surgical removal of the internal limiting membrane in diabetic cystoid macular edema. Retina. 2005;25:454-461.
21. Shah SP, Patel M, Thomas M, et al. Factors predicting outcome of vitrectomy for diabetic macular oedema: results of a prospective study. Br J Ophthalmol. 2006;90:33-36.
22. Patel JI, Hykin PG, Schadt M, et al. Pars plana vitrectomy for diabetic macular oedema: OCT and functional correlations. Eye. 2006;20:674-680.
23. Stolba U, Binder S, Gruber D, et al. Vitrectomy for persistent diffuse diabetic macular edema. Am J Ophthalmol. 2005;140:295-301.
24. Ma J, Yao K, Jiang J, et al. Assessment of macular function by multifocal electroretinogram in diabetic macular edema before and after vitrectomy. Doc Ophthalmol. 2004;109:131-137.
25. Thomas D, Bunce C, Moorman C, Laidlaw DAH. A randomized controlled feasibility trial of vitrectomy versus laser for diabetic macular oedema. Br J Ophthalmol. 2005;89:81-86.
26. Chhablani JK, Kim JS, Cheng L, et al. External limiting membrane as a predictor of visual improvement in diabetic macular edema after pars plana vitrectomy. Graefes Arch Clin Exp Ophthalmol 2012;250:1415-1420.
27. Kim YT, Kang SW, Kim SJ, et al. Combination of vitrectomy, IVTA, and laser photocoagulation for diabetic macular edema unresponsive to prior treatments; 3-year results. Graefes Arch Clin Exp Ophthalmol. 2012;250:679-684.
28. Yanyali A, Horozoglu F, Celik E, et al. Long-term outcomes of pars plana vitrectomy with internal limiting membrane removal in diabetic macular edema. Retina. 2007;27:557-566.
29. Kim YM, Lee SY, Koh HJ. Prediction of postoperative visual outcome after pars plana vitrectomy based on preoperative multifocal electroretinography in eyes with diabetic macular edema. Graefes Arch Clin Exp Ophthalmol. 2010;248:1387-1393.
30. Kumagai K, Furukawa M, Ogino N, et al. Long-term follow-up of vitrectomy for diffuse nontractional diabetic macular edema. Retina. 2009;29:464-472.
31. Naito T, Matsushita S, Sato H, et al. Results of submacular surgery to remove diabetic sub-macular hard exudates. J Med Invest. 2008;55:211-215.
32. Hartley KL, Smiddy WE, Flynn HW, Murray TG. Pars plana vitrectomy with internal limiting membrane peeling for diabetic macular edema. Retina. 2008;28:410-419.
33. Song SH, Sohn JH, Park KH. Evaluation of the efficacy of vitrectomy for persistent diabetic macular edema and associated factor predicting outcome. Kor J Ophthalmol. 2007;21:146-150.
34. Yamamoto T, Takeuchi S, Sato Y, Yamashita H. Long-term follow-up results of pars plana vitrectomy for diabetic macular edema. Jpn J Ophthalmol. 2007;51:285-291.
35. Shimonagano Y, Makiuchi R, Miyazaki M, et al. Results of visual acuity and foveal thickness in diabetic macular edema after vitrectomy. Jpn J Ophthalmol. 2007;51:204-209.
36. Mochizuki Y, Hata Y, Enaida H, et al. Evaluating adjunctive surgical procedures during vitrectomy for diabetic macular edema. Retina. 2006;26:143-148.
37. Kamura Y, Sato Y, Isomae T, Shimada H. Effects of internal limiting membrane peeling in vitrectomy on diabetic cystoid macular edema patients. Jpn J Ophthalmol. 2005;49:297-300.
38. Rosenblatt BJ, Shah GK, Sharma S, Bakal J. Pars plana vitrectomy with internal limiting membranectomy for refractory diabetic macular edema without a taut posterior hyaloid. Graefes Arch Clin Exp Ophthalmol. 2005;243:20-25.
39. Yamamoto T, Hitani K, Tsukahara I, et al. Early postoperative retinal thickness changes and complications after vitrectomy for diabetic macular edema. Am J Ophthalmol. 2003;135:14-19.
40. Sakamoto A, Nishijima K, Kita M, et al. Association between foveal photoreceptor status and visual acuity after resolution of diabetic macular edema by pars plana vitrectomy. Graefes Arch Clin Exp Ophthalmol. 2009;247:1325-1330.
41. Diabetes Retinopathy Clinical Research Network. Expanded 2-year follow-up of ranibizumab plus prompt or deferred laser or triamcinolone plus prompt laser for diabetic macular edema. Ophthalmology. 2011;118:609-614.
42. Mitchell P, Bandello F, Schmidt-Erfurth U, et al. Ranibizumab monotherapy or combined with laser versus laser monotherapy for diabetic macular edema. Ophthalmology. 2011;118:615-625.
43. Michaelides M, Kaines A, Hamilton RD, et al. A prospective randomized trial of intravitreal bevacizumab or laser therapy in the management of diabetic macular edema (BOLT Study). Ophthalmology. 2010;117:1078-1086.
44. Nguyen QD, Shah SM, Khwaja AA, et al. Two-year outcomes of the ranibizumab for edema of the macula in diabetes (READ-2) study. Ophthalmology. 2010;117:2146-2151.
45. Browning DJ, Fraser CM, Powers ME. Comparison of the magnitude and time course of macular thinning induced by different interventions for diabetic macular edema: implications for sequence of application. Ophthalmology. 2006;113:1713-1719.
46. Schneider EW, Geraets RL, Johnson MW. Pars plana vitrectomy without adjuvant procedure for repair of primary rhegmatogenous retinal detachment. Retina. 2012;32:213-219.
47. Tarantola RM, Tsui JY, Graff JM, et al. Intraoperative sclerotomy-related retinal breaks during 23-gauge pars plana vitrectomy. Retina. 2013;33:136-142.
48. Oshima Y, Ohji M, Tano Y. Surgical outcomes of 25-gauge Transconjunctival vitrectomy combined with cataract surgery for vitreoretinal diseases. Ann Acad Med Singapore. 2006;35:175-180.
49. Johnson MW. Posterior vitreous detachment: evolution and role in macular disease. Retina. 2012;32(Suppl 2):S174-S178.
50. Kwok AKH, Leung DYL, Hon C, Lam DSC. Vision threatening vitreous haemorrhage after internal limiting membrane peeling in macular surgeries. Br J Ophthalmol. 2002;86:1449-1450.
51. Mitchell P; RESTORE Extension Study Group. Two-year safety and efficacy outcome of ranibizumab 0.5 mg in patients with visual improvement due to diabetic macular edema (DME): an interim analysis of the RESTORE extension study. Invest Ophthalmol Vis Sci. 2012;53:ARVO E-Abstract 4667.
52. Elman MJ, Qin H, Aiello LP, et al. Intravitreal ranibizumab for diabetic macular edema with prompt versus deferred laser treatment: three-year randomized trial results. Ophthalmology. 2012;119:2312-2318.
53. Lim JH, Wickremasinghe SS, Xie J, et al. Delay to treatment and visual outcomes in patients treated with anti-vascular endothelial growth factor for age-related macular degeneration. Am J Ophthalmol. 2012;153:678-686.
54. Brown DM, Campochiaro PA, Bhisitkul RB, et al. Sustained benefits from ranibizumab for macular edema following branch retinal vein occlusion: 12-month outcomes of a phase III study. Ophthalmology. 2011;118:1594-1602.
55. Hikichi T, Fujio N, Akiba Y, et al. Association between the short-term natural history of diabetic macular edema and the vitreomacular relationship in type 2 diabetes mellitus. Ophthalmology. 1997;104:473-478.
56. Landers MB, Wolbarsht ML. Rubeosis irides: A rationale for panretinal photocoagulation at the time of vitrectomy in diabetes. Ocutome/Fragmatome Newsletter. 1979;4:1-2.
57. Wolbarsht ML, Landers MB: The rationale of photocoagulation therapy for proliferative diabetic retinopathy. A review and a model. Ophthalmic Surg. 1980;11:235-245.
58. Steffanson E, Landers MB, Wolbarsht ML. Increased retinal oxygen supply following pan-retinal photocoagulation and vitrectomy and lensectomy. Trans Am Ophthalmol Soc. 1981;79:307-334.
59. Gisladottir S, Loftsson T, Stefansson E. Diffusion characteristics of vitreous humour and saline solution follow the Stokes Einstein equation. Graefes Arch Clin Exp Ophthalmol. 2009;247:1677-1684.
60. Nasrallah FP, Jalkh AE, VanCoppenrolle F, et al. The role of the vitreous in diabetic macular edema. Ophthalmology. 1988;95:1335-1339.
61. Shimada H, Akaza E, Yuzawa M, Kawashima M. Concentration gradient of vascular endothelial growth factor in the vitreous of eyes with diabetic macular edema. Invest Ophthalmol Vis Sci. 2009;50:2953-2955.
62. Thompson J. Paper presented at the annual meeting of the Retina Society. Washington, DC; October 5, 2012.
63. Mason J. Paper presented at the annual meeting of the Retina Society. Washington, DC; October 5, 2012.
64. Murata T. Paper presented at the Vail Vitrectomy Symposium. Vail, CO; March 18, 2013.








